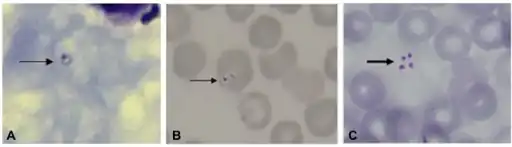

Babesiosis
Babesiosis | |
---|---|
Other names: Babesiasis | |
![]() | |
Babesia | |
![]() | |
Pronunciation |
|
Specialty | Infectious disease |
Symptoms | Fever, chills, headache, fatigue[1] |
Complications | Jaundice,shock, hemoglobinuria,renal dysfunction[2] |
Risk factors | Removed spleen, weakened immune system, doing outdoor activities[1] |
Treatment | Atovaquone plus azithromycin[2] |
Frequency | ~2,000 cases (U.S.)[3] |
Babesiosis or piroplasmosis (or Babesia parasite infection[4]) is a malaria-like parasitic disease caused by infection with a eukaryotic parasite in the order Piroplasmida, typically a Babesia or Theileria, in the phylum Apicomplexa.[5] Human babesiosis transmission via tick bite is most common in the Northeastern and Midwestern United States and parts of Europe, and sporadic throughout the rest of the world. It occurs in warm weather.[6] People can get infected with Babesia parasites by the bite of an infected tick, by getting a blood transfusion from an infected donor of blood products, or by congenital transmission (an infected mother to her baby).[7] Ticks transmit the human strain of babesiosis, so it often presents with other tick-borne illnesses such as Lyme disease.[8] After trypanosomes, Babesia is thought to be the second-most common blood parasite of mammals. They can have major adverse effects on the health of domestic animals in areas without severe winters. In cattle the disease is known as Texas cattle fever or redwater.[9]
Signs and symptoms

Most children and healthy adults (about 25%) with Babesia infection are asymptomatic. When people do develop symptoms, the most common are fever and hemolytic anemia, symptoms that are similar to those of malaria. People with symptoms usually become ill 1 to 4 weeks after the bite. A person infected with babesiosis gradually develops malaise and fatigue, followed by a fever. Hemolytic anemia, in which red blood cells are destroyed and removed from the blood, also develops. Chills, sweats, and thrombocytopenia are also common symptoms. Symptoms may last from several days to several months.[8][10][11]
Less common symptoms and physical exam findings of mild-to-moderate babesiosis:[8][12]
- Headache
- Muscle pain
- Anorexia
- Nonproductive cough
- Arthralgias
- Nausea
- Vomiting
- Sore throat
- Abdominal pain
- Pink eye/Conjunctivitis
- Photophobia
- Weight loss
- Emotional lability
- Depression
- Hyperesthesia
- Enlarged spleen
- Pharyngeal erythema
- Enlarged liver
- Jaundice
- Retinopathy with splinter hemorrhages
- Retinal infarcts
- Neutropenia
In more severe cases, symptoms similar to malaria occur, with fevers around 40.0 °C, shaking chills, and severe anemia. Organ failure may follow, including adult respiratory distress syndrome. Sepsis in people who have had a splenectomy can occur rapidly, consistent with overwhelming post-splenectomy infection. Severe cases are also more likely to occur in the very young, very old, and persons with immunodeficiency, such as HIV/AIDS patients.[2][13]
A reported increase in human babesiosis diagnoses in the 2000s is thought to be caused by more widespread testing and higher numbers of people with immunodeficiencies coming in contact with ticks, the disease vector.[9] Little is known about the occurrence of Babesia species in malaria-endemic areas, where Babesia can easily be misdiagnosed as Plasmodium. Human patients with repeat babesiosis infection may exhibit premunity.[14]
Cause

Babesia,[15][16] also called Nuttallia,[17] is an apicomplexan parasite that infects red blood cells and is transmitted by ticks. Originally discovered by the Romanian bacteriologist Victor Babeș in 1888, over 100 species of Babesia have since been identified.[18][19]
Babesia species are in the phylum Apicomplexa, which also has the protozoan parasites that cause malaria, toxoplasmosis, and cryptosporidiosis.[8] [20]
Four clades of Babesia species infect humans. The main species in each clade are:[21]
- B. microti
- B. duncani
- B. divergens (cattle parasite ) and
- B. venatorum (roe deer parasite)
Pathophysiology

Babesia parasites reproduce in red blood cells, where they can be seen as cross-shaped inclusions (four merozoites asexually budding, but attached together forming a structure) and cause hemolytic anemia, quite similar to malaria.[22][23][24]
Unlike parasites that affect the liver, Babesia species lack an exoerythrocytic phase, so the liver is usually not affected.[23]
In nonhuman animals, Babesia canis rossi, Babesia bigemina, and Babesia bovis cause particularly severe forms of the disease, including a severe haemolytic anaemia, with positive erythrocyte-in-saline-agglutination test indicating an immune-mediated component to the haemolysis. Common sequelae include haemoglobinuria , disseminated intravascular coagulation, and "cerebral babesiosis" caused by sludging of erythrocytes in cerebral capillaries.[25][26][27]
In bovine species, the organism causes hemolytic anemia, so an infected animal shows pale mucous membranes initially. As the levels of bilirubin continue to increase, the visible mucous membranes become yellow in color due to the failure of the liver to metabolize the excess bilirubin. Hemoglobinuria is seen due to excretion of red-blood-cell lysis byproducts via the kidneys. A high fever develops due to release of inflammatory byproducts.[25][27]
Diagnosis
Only specialized laboratories can adequately diagnose Babesia infection in humans, so Babesia infections are considered highly under-reported. It develops in patients who live in or travel to an endemic area or receive a contaminated blood transfusion within the preceding 9 weeks, so this aspect of the medical history is vital.[28] Babesiosis may be suspected when a person with such an exposure history develops persistent fevers and hemolytic anemia. The definitive diagnostic test is the identification of parasites on a Giemsa-stained thin-film blood smear.[28]
So-called "Maltese cross formations" on the blood film are diagnostic (pathognomonic) of babesiosis, since they are not seen in malaria, the primary differential diagnosis.[22] Careful examination of multiple smears may be necessary, since Babesia may infect less than 1% of circulating red blood cells, thus be easily overlooked.[29]
Serologic testing for antibodies against Babesia (both IgG and IgM) can detect low-level infection in cases with a high clinical suspicion, but negative blood film examinations. Serology is also useful for differentiating babesiosis from malaria in cases where people are at risk for both infections. Since detectable antibody responses require about a week after infection to develop, serologic testing may be falsely negative early in the disease course.[30]
A polymerase chain reaction (PCR) test has been developed for the detection of Babesia from the peripheral blood.[31] PCR may be at least as sensitive and specific as blood-film examination in diagnosing babesiosis, though it is also significantly more expensive.[32] Most often, PCR testing is used in conjunction with blood film examination and possibly serologic testing.[28]
In animals, babesiosis is suspected by observation of clinical signs in animals in endemic areas. Diagnosis is confirmed by observation of merozoites on thin film blood smear examined at maximum magnification under oil using Romonovski stains. This is a routine part of the veterinary examination of dogs and ruminants in regions where babesiosis is endemic.Babesia canis and B. bigemina are "large Babesia species" that form paired merozoites in the erythrocytes; their merozoites are around twice the size of small ones.Cerebral babesiosis is suspected in vivo when neurological signs are seen in cattle that are positive for B. bovis on blood smear. Red discoloration of the grey matter post mortem further strengthens suspicion of cerebral babesiosis. Diagnosis is confirmed post mortem by observation of Babesia-infected erythrocytes sludged in the cerebral cortical capillaries in a brain smear.[25][33][34]
Treatment
Treatment of asymptomatic carriers should be considered if parasites are still detected after 3 months. In mild-to-moderate babesiosis, the treatment of choice is a combination of atovaquone and azithromycin. This regimen is preferred to clindamycin and quinine because it has fewer side effects. The standard course is 7 to 10 days, but this is extended to at least 6 weeks in people with relapsing disease. Even mild cases are recommended to be treated to decrease the chance of inadvertently transmitting the infection by donating blood.[8] In severe babesiosis, the combination of clindamycin and quinine is preferred. In life-threatening cases, exchange transfusion is performed.[35] In this procedure, the infected red blood cells are removed and replaced with uninfected ones. Imizol is a drug used for treatment of babesiosis in dogs.[36] Extracts of the poisonous, bulbous plant Boophone disticha are used in the folk medicine of South Africa to treat equine babesiosis. B. disticha is a member of the daffodil family Amaryllidaceae and has also been used in preparations employed as arrow poisons, hallucinogens, and in embalming. The plant is rich in alkaloids, some of which display an action similar to that of scopolamine.[37][2]
- (Proposed) mechanism of action of atovaquone and endochin-like quinolones in Babesia mitochondrion[38]
- Atovaquone
Epidemiology

Babesiosis is a vector-borne illness usually transmitted by Ixodes scapularis ticks. B. microti uses the same tick vector as Lyme disease, and may occur in conjunction with Lyme. The organism can also be transmitted by blood transfusion. Ticks of domestic animals, especially Rhipicephalus (Boophilus) microplus and R. (B.) decoloratus transmit several species of Babesia to livestock, causing considerable economic losses to farmers in tropical and subtropical regions.[9][39][40][41]
In the United States, the majority of babesiosis cases are caused by B. microti, and occur in the Northeast and northern Midwest from May through October.[8] Areas with especially high rates include eastern Long Island, Fire Island, Nantucket Island, and Martha's Vineyard.[42][43][44][45]The Centers for Disease Control and Prevention now requires state health departments to report infections using Form OMB No. 0920-0728 .[46] In 2014, Rhode Island had an incidence of 16.3 reported infections per 100,000 people.[47]
In Europe, B. divergens is the primary cause of infectious babesiosis and is transmitted by I. ricinus.[8]
Babesiosis has emerged in Lower Hudson Valley, New York, since 2001.[48]
In Australia, one locally-acquired case of B. microti has been reported, which was fatal.[49] A subsequent investigation found no additional evidence of human Babesiosis in over 7000 patient samples, leading the authors to conclude that Babesiosis was rare in Australia.[50] A similar disease in cattle, commonly known as tick fever, is spread by Babesia bovis and B. bigemina in the introduced cattle tick Rhipicephalus microplus. This disease is found in eastern and northern Australia.[51]
Isolated cases

A table of isolated cases of babesiosis, which may be underestimated given how widely distributed the tick vectors are in temperate latitudes:[8][52][50]
Location | Species |
---|---|
Pacific Coast (northern California to Washington) | B. duncani |
Kentucky, Missouri, and Washington | B. divergens |
Austria, Germany, Italy | B. venatorum |
Canary islands | B. microti |
Africa (Egypt, Mozambique | Uncharacterized spp. |
Asia (Taiwan, Japan) | B. microti |
South Korea | Babesia KO1 |
Australia | B. microti |
South America (Brazil, Colombia) | Uncharacterized spp. |
History

The disease is named for the genus of the causative organism,[53] which was named after the Romanian bacteriologist Victor Babeș.[54] In 1888, Victor Babeș identified the microorganisms in red blood cells as the cause of febrile hemoglobinuria in cattle.[8] In 1893, Theobald Smith and Frederick Kilborne discovered that a tick was the vector for transmission in Texas cattle. The agent was B. bigemina. This was the first demonstration that an arthropod could act as a disease vector to transmit an infectious agent to a vertebrate host.[55][56]
In 1957, the first human case was documented in a splenectomized Croatian herdsman. The agent was B. divergens. In 1969, the first case was reported in an immunocompetent individual on Nantucket Island. The agent was B. microti, and the vector was the tick I. scapularis. Equine babesiosis caused by the protozoan Theileria equi is also known as piroplasmosis, from the Latin piro, meaning pear + Greek plasma, a thing formed.[57][58][8]
Other animals
Veterinary treatment of babesiosis does not normally use antibiotics. In livestock and animals, diminazen (Berenil), imidocarb, or trypan blue would be the drugs of choice for treatment of B. canis rossi , B. bovis, and B. bigemina .[25][59]
A vaccine is effective against B. canis canis in current research[60]
References
- 1 2 "CDC - Babesiosis". Centers for Disease Control and Prevention. Archived from the original on 2021-03-08. Retrieved 2021-02-25.
- 1 2 3 4 5
- ↑ "Surveillance for Babesiosis —2020" (PDF). cdc. Archived (PDF) from the original on 19 September 2023. Retrieved 24 November 2023.
- ↑ "Babesiosis (Concept Id: C0004576) - MedGen - NCBI". www.ncbi.nlm.nih.gov. Archived from the original on 25 November 2023. Retrieved 22 November 2023.
- ↑ Berger, Stephen A.; Marr, John S. (2006). Human Parasitic Diseases Sourcebook. Jones & Bartlett Learning. ISBN 978-0-7637-2962-2. Archived from the original on 2013-11-13. Retrieved 2016-10-14.
- ↑ Prevention, CDC - Centers for Disease Control and. "CDC - Babesiosis". www.cdc.gov. Archived from the original on 2015-10-25. Retrieved 2015-10-25.
- ↑ Prevention, CDC - Centers for Disease Control and. "CDC2 - Babesiosis" (PDF). www.cdc.gov. Archived (PDF) from the original on 2018-07-27. Retrieved 2018-09-20.
- 1 2 3 4 5 6 7 8 9 10 Vannier, Edouard; Krause, Peter J. (21 June 2012). "Human Babesiosis" (PDF). New England Journal of Medicine. 366 (25): 2397–2407. doi:10.1056/NEJMra1202018. PMID 22716978. S2CID 205116383. Archived (PDF) from the original on 2021-11-12.
- 1 2 3 Hunfeld KP, Hildebrandt A, Gray JS (2008). "Babesiosis: Recent insights into an ancient disease". Int J Parasitol. 38 (11): 1219–37. doi:10.1016/j.ijpara.2008.03.001. PMID 18440005.
- ↑ "Babesiosis | Tick-borne Diseases | Ticks | CDC". www.cdc.gov. 9 August 2022. Archived from the original on 30 June 2023. Retrieved 24 November 2023.
- ↑ "Babesiosis - Symptoms, Causes, Treatment | NORD". rarediseases.org. Archived from the original on 2023-03-26. Retrieved 2023-12-02.
- ↑ Wormser GP, et al. (2015). "Neutropenia in congenital and adult babesiosis". Am J Clin Pathol. 144 (1): 94–96. doi:10.1309/AJCP2PHH4HBVHZFS. PMID 26071466. Archived from the original on 2019-12-18. Retrieved 2015-08-19.
- ↑ Yune, Philip S.; Islam, Iffath; Dicpinigaitis, Peter V.; Daily, Johanna P.; Weiss, Louis M.; Park, Sun O. (12 November 2022). "A Case Report and Literature Review of Babesiosis-Induced Acute Respiratory Distress Syndrome". Case Reports in Infectious Diseases. 2022: 4318731. doi:10.1155/2022/4318731. ISSN 2090-6625. Archived from the original on 12 April 2023. Retrieved 3 December 2023.
- ↑ Shaw, Susan E.; Day, Michael J. (11 April 2005). Arthropod-borne Infectious Diseases of the Dog and Cat. Manson Publishing. p. 71. ISBN 978-1-84076-578-6. Archived from the original on 26 June 2014. Retrieved 14 October 2016.
- ↑ Khayat, Abeer; Rathore, Mobeen (2008). "Ch. 36: Babesia Species". In Barton, Leslie L.; Volpe, J. J.; Friedman, Neil R. (eds.). The Neurological Manifestations of Pediatric Infectious Diseases and Immunodeficiency Syndromes. Humana Press. pp. 343–6. ISBN 978-1-59745-391-2. Archived from the original on 2023-06-30. Retrieved 2023-03-18.
- ↑ "Babesia". NCBI Taxonomy Browser. 5864. Archived from the original on 2019-01-02. Retrieved 2023-03-18.
- ↑ Nowell, Frank (November 1969). "The blood picture resulting from Nuttallia (= Babesia) rodhaini and Nuttallia (= Babesia) microti infections in rats and mice". Parasitology. 59 (4): 991–1004. doi:10.1017/S0031182000070475. PMID 4982449. S2CID 43157316.
- ↑ "DPDx: Laboratory Identification of Parasites of Public Health Concern. Babesiosis". CDC. 2009-03-05. Archived from the original on 2013-03-07.
- ↑ Anand, K. P.; Anand, A.; Kashyap, A. S. (March 2015). "Dr. Victor Babes, Discoverer of Babesia". The Journal of the Association of Physicians of India. 63 (3): 80–81. ISSN 0004-5772. Archived from the original on 2021-07-11. Retrieved 2023-12-01.
- ↑ Kloehn, Joachim; Harding, Clare R.; Soldati-Favre, Dominique (January 2021). "Supply and demand-heme synthesis, salvage and utilization by Apicomplexa". The FEBS journal. 288 (2): 382–404. doi:10.1111/febs.15445. ISSN 1742-4658. Archived from the original on 2023-12-06. Retrieved 2023-12-04.
- ↑ Montero, Estrella; Gray, Jeremy; Lobo, Cheryl Ann; González, Luis Miguel (25 March 2022). "Babesia and Human Babesiosis". Pathogens. 11 (4): 399. doi:10.3390/pathogens11040399. ISSN 2076-0817. Archived from the original on 25 November 2023. Retrieved 24 November 2023.
- 1 2 Noskoviak K, Broome E (2008). "Images in clinical medicine. Babesiosis". N Engl J Med. 358 (17): e19. doi:10.1056/NEJMicm070903. PMID 18434647.
- 1 2 Ortiz, Juan Fernando; Millhouse, Paul W; Morillo Cox, Álvaro; Campoverde, Leticia; Kaur, Arveen; Wirth, Martín; Atoot, Adam. "Babesiosis: Appreciating the Pathophysiology and Diverse Sequela of the Infection". Cureus. 12 (10): e11085. doi:10.7759/cureus.11085. ISSN 2168-8184. Archived from the original on 2023-11-28. Retrieved 2023-11-26.
- ↑ Vannier, Edouard G.; Diuk-Wasser, Maria A.; Ben Mamoun, Choukri; Krause, Peter J. (2015). "Babesiosis". Infectious disease clinics of North America. 29 (2): 357–370. doi:10.1016/j.idc.2015.02.008. ISSN 0891-5520. Archived from the original on 2022-12-16. Retrieved 2023-12-06.
- 1 2 3 4 "Babesiosis in Animals - Circulatory System". Merck Veterinary Manual. Archived from the original on 2023-06-10. Retrieved 2023-11-27.
- ↑ Bajer, Anna; Dwużnik-Szarek, Dorota (28 September 2021). "The specificity of Babesia-tick vector interactions: recent advances and pitfalls in molecular and field studies". Parasites & Vectors. 14 (1): 507. doi:10.1186/s13071-021-05019-3. ISSN 1756-3305. Archived from the original on 2 November 2021. Retrieved 28 November 2023.
- 1 2 Young, Kaitlin M.; Corrin, Tricia; Wilhelm, Barbara; Uhland, Carl; Greig, Judy; Mascarenhas, Mariola; Waddell, Lisa A. (2019). "Zoonotic Babesia: A scoping review of the global evidence". PloS One. 14 (12): e0226781. doi:10.1371/journal.pone.0226781. ISSN 1932-6203. Archived from the original on 2023-04-16. Retrieved 2023-12-05.
- 1 2 3 Wormser GP, Dattwyler RJ, Shapiro ED, et al. (November 2006). "The clinical assessment, treatment, and prevention of Lyme disease, human granulocytic anaplasmosis, and babesiosis: clinical practice guidelines by the Infectious Diseases Society of America" (PDF). Clin. Infect. Dis. 43 (9): 1089–134. doi:10.1086/508667. PMID 17029130. Archived (PDF) from the original on 2020-07-26. Retrieved 2019-09-20.
- ↑ Krause PJ (2003). "Babesiosis diagnosis and treatment". Vector Borne Zoonotic Dis. 3 (1): 45–51. doi:10.1089/153036603765627451. PMID 12804380.
- ↑ Krause PJ, Telford SR, Ryan R, et al. (April 1994). "Diagnosis of babesiosis: evaluation of a serologic test for the detection of Babesia microti antibody". J. Infect. Dis. 169 (4): 923–6. doi:10.1093/infdis/169.4.923. PMID 8133112.
- ↑ Persing DH, Mathiesen D, Marshall WF, et al. (August 1992). "Detection of Babesia microti by polymerase chain reaction". J. Clin. Microbiol. 30 (8): 2097–103. doi:10.1128/jcm.30.8.2097-2103.1992. PMC 265450. PMID 1500517.
- ↑ Krause PJ, Telford S, Spielman A, et al. (November 1996). "Comparison of PCR with blood smear and inoculation of small animals for diagnosis of Babesia microti parasitemia". J. Clin. Microbiol. 34 (11): 2791–4. doi:10.1128/jcm.34.11.2791-2794.1996. PMC 229405. PMID 8897184.
- ↑ Bajer, Anna; Beck, Ana; Beck, Relja; Behnke, Jerzy M.; Dwużnik-Szarek, Dorota; Eichenberger, Ramon M.; Farkas, Róbert; Fuehrer, Hans-Peter; Heddergott, Mike; Jokelainen, Pikka; Leschnik, Michael; Oborina, Valentina; Paulauskas, Algimantas; Radzijevskaja, Jana; Ranka, Renate; Schnyder, Manuela; Springer, Andrea; Strube, Christina; Tolkacz, Katarzyna; Walochnik, Julia (May 2022). "Babesiosis in Southeastern, Central and Northeastern Europe: An Emerging and Re-Emerging Tick-Borne Disease of Humans and Animals". Microorganisms. 10 (5): 945. doi:10.3390/microorganisms10050945. ISSN 2076-2607. Archived from the original on 2023-02-22. Retrieved 2023-12-08.
- ↑ Taboada, Joseph; Merchant, Sandra R. (1 January 1991). "Babesiosis of Companion Animals and Man". Veterinary Clinics of North America: Small Animal Practice. 21 (1): 103–123. doi:10.1016/S0195-5616(91)50011-5. ISSN 0195-5616. Archived from the original on 9 December 2023. Retrieved 8 December 2023.
- ↑ Tanyel, Esra; Guler, Nil; Hokelek, Murat; Ulger, Fatma; Sunbul, Mustafa (2015). "A case of severe babesiosis treated successfully with exchange transfusion". Int J Infect Dis. 38: 83–5. doi:10.1016/j.ijid.2015.07.019. PMID 26232090.
- ↑ "Imizol | Overview". Merck Animal Health. Archived from the original on 7 August 2015. Retrieved 15 August 2015.
- ↑ Duke, James A. ""Boophone disticha" (Liliaceae)". Dr. Duke's Phytochemical and Ethnobotanical Databases. Archived from the original on January 15, 2018. Retrieved November 10, 2011.
- ↑ Renard, Isaline; Ben Mamoun, Choukri (1 September 2021). "Treatment of Human Babesiosis: Then and Now". Pathogens. 10 (9): 1120. doi:10.3390/pathogens10091120. ISSN 2076-0817. Archived from the original on 25 November 2023. Retrieved 25 November 2023.
- 1 2 Kumar, Abhinav; O’Bryan, Jane; Krause, Peter J. (November 2021). "The Global Emergence of Human Babesiosis". Pathogens. 10 (11): 1447. doi:10.3390/pathogens10111447. ISSN 2076-0817.
- ↑ Herwaldt BL, Linden JV, Bosserman E, Young C, Olkowska D, Wilson M (2011). "Transfusion-associated babesiosis in the United States: a description of cases". Ann Intern Med. 155 (8): 509–19. doi:10.7326/0003-4819-155-8-201110180-00362. PMID 21893613.
- ↑ Leiby DA (2011). "Transfusion-associated babesiosis: shouldn't we be ticked off?". Ann Intern Med. 155 (8): 556–7. doi:10.7326/0003-4819-155-8-201110180-00363. PMID 21893616.
- ↑ Giannini, A. James; Black, Henry R.; Goettsche, Roger L. (1978). Psychiatric, psychogenic, and somatopsychic disorders handbook: a laboratory and clinical guide to the medical management of emotional and intellectual pathology. Medical Examination. p. 86. ISBN 978-0-87488-596-5. Archived from the original on 2020-07-26. Retrieved 2016-10-14.
- ↑ Belluck, Pam (September 6, 2009). "Tick-Borne Illnesses Have Nantucket Considering Some Deer-Based Solutions". The New York Times. Archived from the original on November 15, 2011. Retrieved September 6, 2009.
- ↑ Herwaldt BL, Persing DH, Précigout EA, et al. (1996). "A fatal case of babesiosis in Missouri: Identification of another piroplasm that infect humans". Annals of Internal Medicine. 124 (7): 643–50. doi:10.7326/0003-4819-124-7-199604010-00004. PMID 8607592. S2CID 46733758.
- ↑ Mylonakis E (May 2001). "When to suspect and how to monitor babesiosis". Am Fam Physician. 63 (10): 1969–74. PMID 11388711. Archived from the original on 2022-07-21. Retrieved 2012-05-26.
- ↑ "Parasites - Babesiosis: National Surveillance". Centers for Disease Control and Prevention. Archived from the original on December 16, 2017. Retrieved 19 June 2018.
- ↑ Centers for Disease Control and Prevention. "Data & Statistics". Center. Archived from the original on 19 June 2018. Retrieved 19 June 2018.
- ↑ Joseph JT, Roy SS, Shams N, Visintainer P, Nadelman RB, Hosur S, et al. (May 2011). "Babesiosis in Lower Hudson Valley, New York, USA". Emerg Infect Dis. 17 (5): 843–7. doi:10.3201/eid1705.101334. PMC 3321771. PMID 21529393.
Related news articles: Laurie Tarkan (June 20, 2011). "Once Rare, Infection by Tick Bites Spreads". The New York Times. Archived from the original on November 25, 2016. Retrieved February 24, 2017. - ↑ Senanayake, Sanjaya N; et al. (March 2012). "First report of human babesiosis in Australia". Medical Journal of Australia. 196 (5): 350–352. doi:10.5694/mja11.11378. PMID 22432676. S2CID 33068508.
- 1 2 Faddy, Helen M.; et al. (July 2019). "No evidence for widespread Babesia microti transmission in Australia". Transfusion. 59 (7): 2368–2374. doi:10.1111/trf.15336. PMID 31070793. S2CID 148570372.
- ↑ Queensland Government, Department of Primary Industries and Fisheries. "Tick fever (bovine babesiosis)". Archived from the original on 5 April 2011. Retrieved 21 February 2012.
- ↑ Kim JY, Cho SH, Joo HN, et al. (June 2007). "First case of human babesiosis in Korea: detection and characterization of a novel type of Babesia sp. (KO1) similar to ovine babesia". J. Clin. Microbiol. 45 (6): 2084–7. doi:10.1128/JCM.01334-06. PMC 1933034. PMID 17392446.
- ↑ "babesia" Archived 2022-04-24 at the Wayback Machine at Merriam-Webster online.
- ↑ Victor Babeș at Who Named It?
- ↑ Schultz, Myron (December 2008). "Photo Quiz: Theobald Smith". Emerg Infect Dis. 14 (12): 1940–1942. doi:10.3201/eid1412.081188. ISSN 1080-6059. PMC 2634653.
- ↑ Assadian, Ojan; Stanek, Gerold (31 July 2002). "Theobald Smith--the discoverer of ticks as vectors of disease". Wiener Klinische Wochenschrift. 114 (13–14): 479–481. ISSN 0043-5325. Archived from the original on 21 January 2022. Retrieved 1 December 2023.
- ↑ "Definition of Piroplasma". lexic.us. Archived from the original on November 11, 2011. Retrieved November 9, 2011.
- ↑ "Equine Piroplasmosis". aphis.usda.gov. Archived from the original on 8 February 2023. Retrieved 7 December 2023.
- ↑ Ayoob, Ashley L.; Hackner, Susan G.; Prittie, Jennifer (February 2010). "Clinical management of canine babesiosis". Journal of Veterinary Emergency and Critical Care (San Antonio, Tex.: 2001). 20 (1): 77–89. doi:10.1111/j.1476-4431.2009.00489.x. ISSN 1476-4431. Archived from the original on 2022-06-17. Retrieved 2023-12-04.
- ↑ Stranahan, Lauren W.; Chaki, Sankar P.; Garcia-Gonzalez, Daniel G.; Khalaf, Omar H.; Arenas-Gamboa, Angela M. (20 May 2020). "Evaluation of the Efficacy of the Brucella canis RM6/66 ΔvjbR Vaccine Candidate for Protection against B. canis Infection in Mice". mSphere. 5 (3): e00172–20. doi:10.1128/mSphere.00172-20. ISSN 2379-5042. Archived from the original on 21 February 2023. Retrieved 27 November 2023.
Further reading
- Center for Global Health (2019-06-25). "Babesiosis". Parasites and Health, DPDx—Laboratory Identification of Parasites of Public Health Concern. Centers for Disease Control & Prevention. Archived from the original on 2013-03-07. Retrieved 2003-10-07. Public domain source from which the first version of this article was derived.
- Krause, Peter J; et al. (27 January 2021). "Clinical Practice Guidelines by the Infectious Diseases Society of America (IDSA): 2020 Guideline on Diagnosis and Management of Babesiosis". Clinical Infectious Diseases. 72 (2): e49–e64. doi:10.1093/cid/ciaa1216. PMID 33252652. Archived from the original on 20 June 2022. Retrieved 19 August 2022.
- Homer MJ, Aguilar-Delfin I, Telford SR, Krause PJ, Persing DH (July 2000). "Babesiosis". Clin. Microbiol. Rev. 13 (3): 451–69. doi:10.1128/CMR.13.3.451-469.2000. PMC 88943. PMID 10885987.
- "Babesiosis: Overview"—The Merck Veterinary Manual
External links
- Current status of Equine piroplasmosis worldwide at OIE. WAHID Interface—OIE World Animal Health Information Database
- Disease card Archived 2022-08-12 at the Wayback Machine—OIE
![]() |
Wikispecies has information related to Babesia |
Classification | |
---|---|
External resources |
|